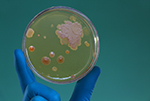

| Broadcast Date | Image | Episode Title | Episode # |
|---|---|---|---|
| May 4, 2018 |
 Image for Robot Surgeons
Image for Robot Surgeons
|
Robot Surgeons | 597 |
| Apr 27, 2018 |
 Image for Blood Pressure is Skin Deep
Image for Blood Pressure is Skin Deep
|
Blood Pressure is Skin Deep | 596 |
| Apr 20, 2018 |
 Image for Chopin's Telltale Heart
Image for Chopin's Telltale Heart
|
Chopin's Telltale Heart | 595 |
| Apr 13, 2018 |
 Image for Can Alzheimer's Be Infectious
Image for Can Alzheimer's Be Infectious
|
Can Alzheimer's Be Infectious | 594 |
| Apr 6, 2018 |
 Image for Sporty Pathogens
Image for Sporty Pathogens
|
Sporty Pathogens | 593 |
| Mar 30, 2018 |
 Image for Can a Dot Help Treat Infection?
Image for Can a Dot Help Treat Infection?
|
Can a Dot Help Treat Infection? | 592 |
| Mar 22, 2018 |
 Image for CRISPR to the Rescue
Image for CRISPR to the Rescue
|
CRISPR to the Rescue | 591 |
| Mar 16, 2018 |
 Image for Making Surgery Survivable
Image for Making Surgery Survivable
|
Making Surgery Survivable | 590 |
| Mar 9, 2018 |
 Image for The Neanderthal in Us
Image for The Neanderthal in Us
|
The Neanderthal in Us | 589 |
| Mar 2, 2018 |
 Image for Who Says Biomedical Research Doesn't Pay?
Image for Who Says Biomedical Research Doesn't Pay?
|
Who Says Biomedical Research Doesn't Pay? | 588 |
| Feb 23, 2018 |
 Image for I Scream From Ice Cream
Image for I Scream From Ice Cream
|
I Scream From Ice Cream | 587 |
| Feb 16, 2018 |
 Image for It's Not Just For the Common Cold Anymore
Image for It's Not Just For the Common Cold Anymore
|
It's Not Just For the Common Cold Anymore | 586 |
| Feb 9, 2018 |
 Image for How Cats Found Their Way In
Image for How Cats Found Their Way In
|
How Cats Found Their Way In | 585 |
| Feb 2, 2018 |
 Image for Taking Advantage of Side Effects
Image for Taking Advantage of Side Effects
|
Taking Advantage of Side Effects | 584 |
| Jan 26, 2018 |
 Image for When Is a Drug Worth a Fortune
Image for When Is a Drug Worth a Fortune
|
When Is a Drug Worth a Fortune | 583 |
| Jan 19, 2018 |
 Image for Zipcode Lifespan
Image for Zipcode Lifespan
|
Zipcode Lifespan | 582 |
| Jan 12, 2018 |
 Image for Another Bloody Epidemic
Image for Another Bloody Epidemic
|
Another Bloody Epidemic | 581 |
| Jan 5, 2018 |
 Image for Nobel 2017
Image for Nobel 2017
|
Nobel 2017 | 580 |
| Dec 29, 2017 |
 Image for Phone Biome
Image for Phone Biome
|
Phone Biome | 579 |
| Dec 22, 2017 |
 Image for Cold Case Solved: Ramses III
Image for Cold Case Solved: Ramses III
|
Cold Case Solved: Ramses III | 342 |
| Dec 15, 2017 |
Image for Leave the Enemy at the Door
Image for Leave the Enemy at the Door
|
Leave the Enemy at the Door | 578 |
| Dec 8, 2017 |
 Image for Tallest Men in the World
Image for Tallest Men in the World
|
Tallest Men in the World | 577 |
| Dec 1, 2017 |
 Image for A New Window into Cells
Image for A New Window into Cells
|
A New Window into Cells | 576 |
| Nov 24, 2017 |
 Image for Implantable Biodegradable Batteries
Image for Implantable Biodegradable Batteries
|
Implantable Biodegradable Batteries | 575 |
| Nov 17, 2017 |
 Image for The Deadly Designer Opiods
Image for The Deadly Designer Opiods
|
The Deadly Designer Opiods | 574 |
| Nov 7, 2017 |
 Image for Venom for Stroke
Image for Venom for Stroke
|
Venom for Stroke | 573 |
| Nov 3, 2017 |
 Image for The Mad King
Image for The Mad King
|
The Mad King | 572 |
| Oct 27, 2017 |
 Image for Restoring Retinas
Image for Restoring Retinas
|
Restoring Retinas | 571 |
| Oct 20, 2017 |
 Image for Americans Support Biomedical Research
Image for Americans Support Biomedical Research
|
Americans Support Biomedical Research | 570 |
| Oct 31, 2017 |
 Image for Hope for a Fatal Brain Cancer
Image for Hope for a Fatal Brain Cancer
|
Hope for a Fatal Brain Cancer | 569 |
| Oct 6, 2017 |
 Image for A Signpost for Sepsis
Image for A Signpost for Sepsis
|
A Signpost for Sepsis | 568 |
| Sep 29, 2017 |
 Image for Phantom Limb in Virtual Reality
Image for Phantom Limb in Virtual Reality
|
Phantom Limb in Virtual Reality | 567 |
| Sep 22, 2017 |
 Image for What We're Really Swimming In
Image for What We're Really Swimming In
|
What We're Really Swimming In | 566 |
| Sep 15, 2017 |
 Image for Science Under Attack
Image for Science Under Attack
|
Science Under Attack | 565 |
| Sep 8, 2017 |
 Image for How the Worm Got Away
Image for How the Worm Got Away
|
How the Worm Got Away | 564 |
| Sep 1, 2017 |
 Image for Saved by the Light
Image for Saved by the Light
|
Saved by the Light | 563 |
| Aug 25, 2017 |
 Image for Fall of the Aztecs
Image for Fall of the Aztecs
|
Fall of the Aztecs | 562 |
| Aug 18, 2017 |
 Image for Mad Cow Blood Test
Image for Mad Cow Blood Test
|
Mad Cow Blood Test | 561 |
| Aug 11, 2017 |
 Image for Double Dip Yuck
Image for Double Dip Yuck
|
Double Dip Yuck | 560 |
| Aug 4, 2017 |
 Image for PET for the Head
Image for PET for the Head
|
PET for the Head | 559 |
| Jul 28, 2017 |
 Image for Rapid Diagnosis of MS
Image for Rapid Diagnosis of MS
|
Rapid Diagnosis of MS | 558 |
| Jul 21, 2017 |
 Image for E-cigarettes and Your Heart
Image for E-cigarettes and Your Heart
|
E-cigarettes and Your Heart | 557 |
| Jul 14, 2017 |
 Image for Your Eyes Got Rhythm
Image for Your Eyes Got Rhythm
|
Your Eyes Got Rhythm | 556 |
| Jul 7, 2017 |
 Image for Standardized Stem Cells
Image for Standardized Stem Cells
|
Standardized Stem Cells | 555 |
| Jun 30, 2017 |
 Image for Mothers Lose Their Minds - It's a Good Thing
Image for Mothers Lose Their Minds - It's a Good Thing
|
Mothers Lose Their Minds - It's a Good Thing | 554 |
| Jun 23, 2017 |
 Image for Lack of Zinc Killed Them
Image for Lack of Zinc Killed Them
|
Lack of Zinc Killed Them | 553 |
| Jun 16, 2017 |
 Image for Eyes in Space
Image for Eyes in Space
|
Eyes in Space | 552 |
| Jun 9, 2017 |
 Image for A CO Antidote
Image for A CO Antidote
|
A CO Antidote | 551 |
| Jun 2, 2017 |
 Image for Zika Is More Than Microcephaly
Image for Zika Is More Than Microcephaly
|
Zika Is More Than Microcephaly | 550 |
| May 26, 2017 |
 Image for Eliminating Human Genetic Diseases
Image for Eliminating Human Genetic Diseases
|
Eliminating Human Genetic Diseases | 549 |
| May 19, 2017 |
 Image for Duck-Billed Diabetes Treatment
Image for Duck-Billed Diabetes Treatment
|
Duck-Billed Diabetes Treatment | 548 |
| May 12, 2017 |
 Image for Energized Energy Drinks
Image for Energized Energy Drinks
|
Energized Energy Drinks | 547 |
| May 5, 2017 |
 Image for You Think Your Commute Is Tough?
Image for You Think Your Commute Is Tough?
|
You Think Your Commute Is Tough? | 546 |
